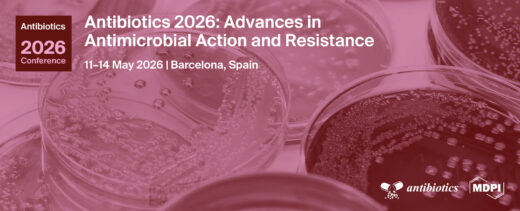

News
37th Brazilian Homeopathy Congress
2 April 2026
HRI Chairman, Dr Alexander Tournier, will be giving an online presentation at the 37th Brazilian Homeopathy Congress....
More
Integrative Personalised Medicine Workshop
2 April 2026
Rachel Roberts will be speaking at a workshop on ‘Subjective Success, Objective Evidence: Combined Insights from Practical Experience and Sci...
More
Antibiotics 2026: Advances in Antimicrobial Action and Resistance
2 April 2026
HRIs Clinical Research Lead, Dr Esther van der Werf will be presenting a poster at Antibiotics 2026: Advances in Antimicrobial Action and Resistanc...
More
LMHI’s 79th Homeopathic Medicine Congress
26 March 2026
HRI’s Rachel Roberts will be presenting at the LMHI’s 79th Homeopathic Medicine Congress...
More
International Conference on Homeopathy in Agriculture and Environment 2026
26 March 2026
HRI’s Dr Alexander Tournier will be presenting at the International Conference on Homeopathy in Agriculture and Environment 2026, an event co...
More
3rd International AYUSH Conference & Exhibition
27 January 2026
Rachel Roberts will be presenting at the 3rd IACE in Dubai, UAE...
More
12th International CEDH Conference
11 September 2025
HRI’s Dr Alexander Tournier and Rachel Roberts will be presenting at the 12th International CEDH Conference....
More
AIH Conference 2025: Homeopathy – Groundbreaking Science and Global Health
22 July 2025
HRI’s Rachel Roberts, Dr Esther van der Werf and Dr Alexander Tournier will be presenting at the AIH Conference....
More
Homeopathic Association of South Africa (HSA) Congress 2025
22 July 2025
HRI’s Dr Alexander Tournier and Rachel Roberts will present at the HSA Congress 2025....
More



